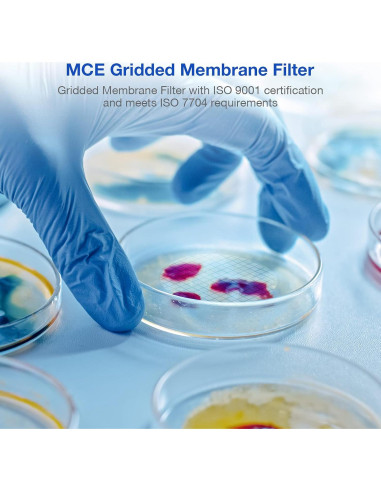
Filtro de Membrana Estéril SimPure MCE 47mm 0.45um Paquete 100
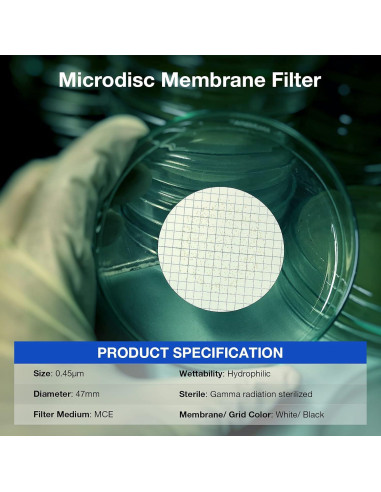
Filtro de Membrana Estéril SimPure MCE 47mm 0.45um Paquete 100
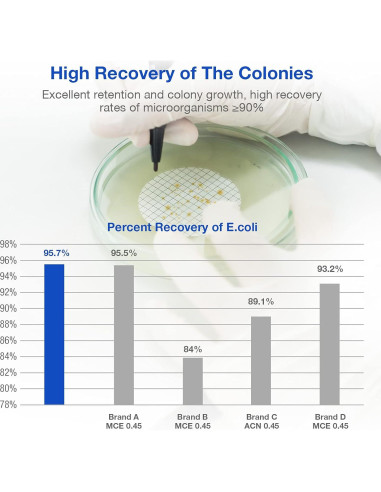
Filtro de Membrana Estéril SimPure MCE 47mm 0.45um Paquete 100
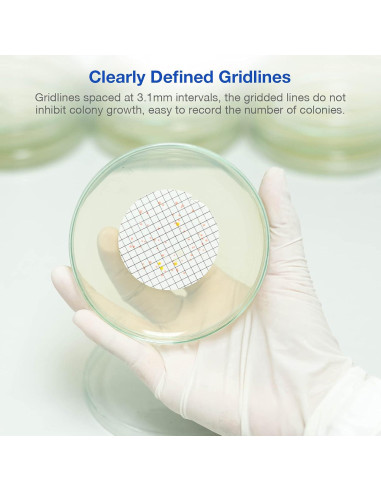
Filtro de Membrana Estéril SimPure MCE 47mm 0.45um Paquete 100

Carrito
No hay más artículos en su carrito
Características destacadas
- El filtro de membrana de éster de celulosa mixta (MCE) SimPure está compuesto de acetato de celulosa y nitrato de celulosa. La membrana MCE es biológicamente inerte, es una de las membranas más utilizadas en aplicaciones analíticas y de investigación
- Los filtros con rejilla tienen líneas de rejilla claramente definidas espaciadas a intervalos de 3.1 mm. La tinta especial utilizada es no tóxica y completamente libre de inhibidores de crecimiento bacteriano
- Las membranas de éster de celulosa mixta (MCE) con rejilla son ideales para el conteo de colonias y pruebas de esterilidad
- Las líneas de rejilla en la superficie de la membrana eliminan la fatiga visual durante el conteo de colonias sin afectar el crecimiento de las colonias. Y permiten que las reacciones de color se observen fácilmente
- Las membranas MCE estériles con rejilla son membranas no soportadas, naturalmente hidrofílicas
Modelo de esta publicación
- Número de artículos: 100
Especificaciones técnicas
- Número de artículos: 100
- Fabricante: Alberts Filter
- Número de modelo del artículo: FMCE047045GWS-100P
- Está descontinuado por el fabricante: No
- Peso: 0.2 kg
- Dimensiones: Ancho: 8.89 cm, Alto: 8.26 cm, Profundidad: 4.45 cm